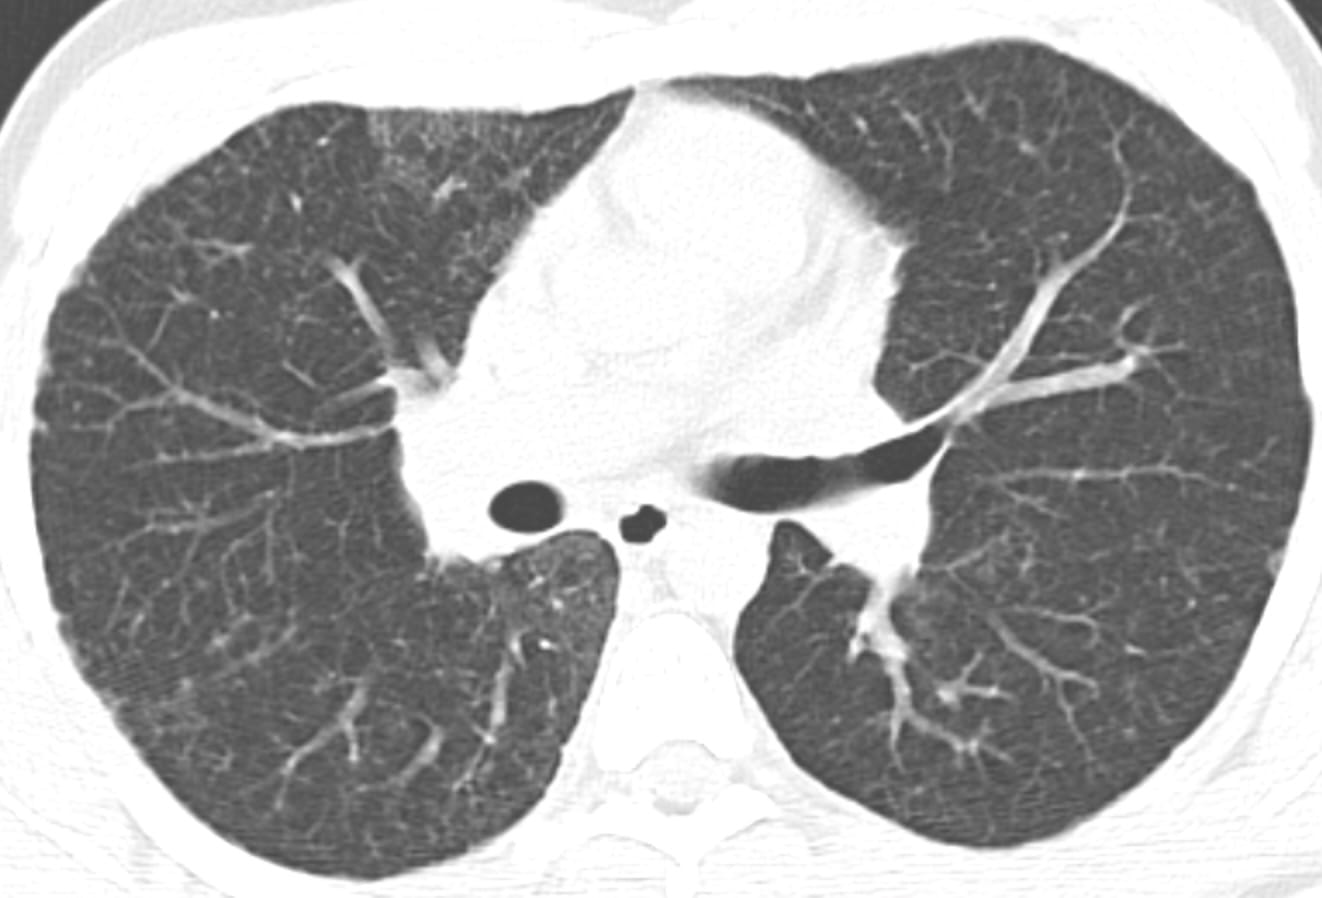

Content
- Imaging features of common chronic, fibrosing interstitial disorders
- Sarcoidosis and Fibrosing Pneumoconioses
- Usual Interstitial Pneumonia
- Fibrotic Non-Specific Interstitial Pneumonia
- Fibrotic Hypersensitivity Pneumonitis
- Smoking-Related Interstitial Fibrosis
- Unusual causes of chronic interstitial fibrosis
- Familial Pulmonary Fibrosis
- Short Telomere Syndromes (Telemeropathies)
- Surfactant protein-related mutations; COPA syndrome; Hermansky-Pudlak
- Pleuropulmonary Fibroelastosis
- Interstitial fibrosis with non-emphysematous lung cysts
- New concepts in Interstitial Fibrosis
- Interstitial Lung Abnormalities
- Progressive Pulmonary Fibrosis
- An update (ATS/ERS) of the classification of the Interstitial Pneumonias
- LIP – R.I.P.

Surveillance CT in context.
Surveillance CT in context.



